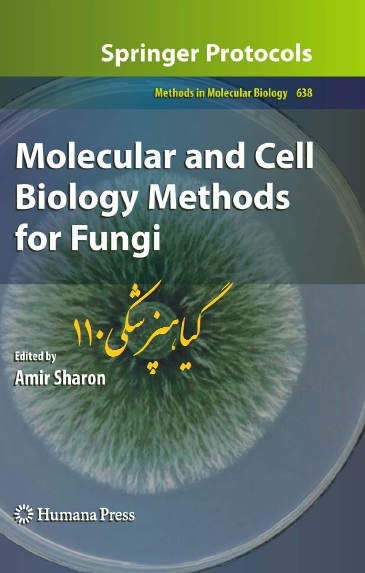

دانلود کتاب کنترل کردن اتمسفر انبار میوه ها و سبزیجات(Controlled Atmosphere Storage of Fruits and Ve
دانلود کتاب کنترل کردن اتمسفر انبار میوه ها و سبزیجات
(Controlled Atmosphere Storage of Fruits and Vegetables)


برای دانلود فایل مورد نظر بر روی ادامه مطلب کلیک کنید